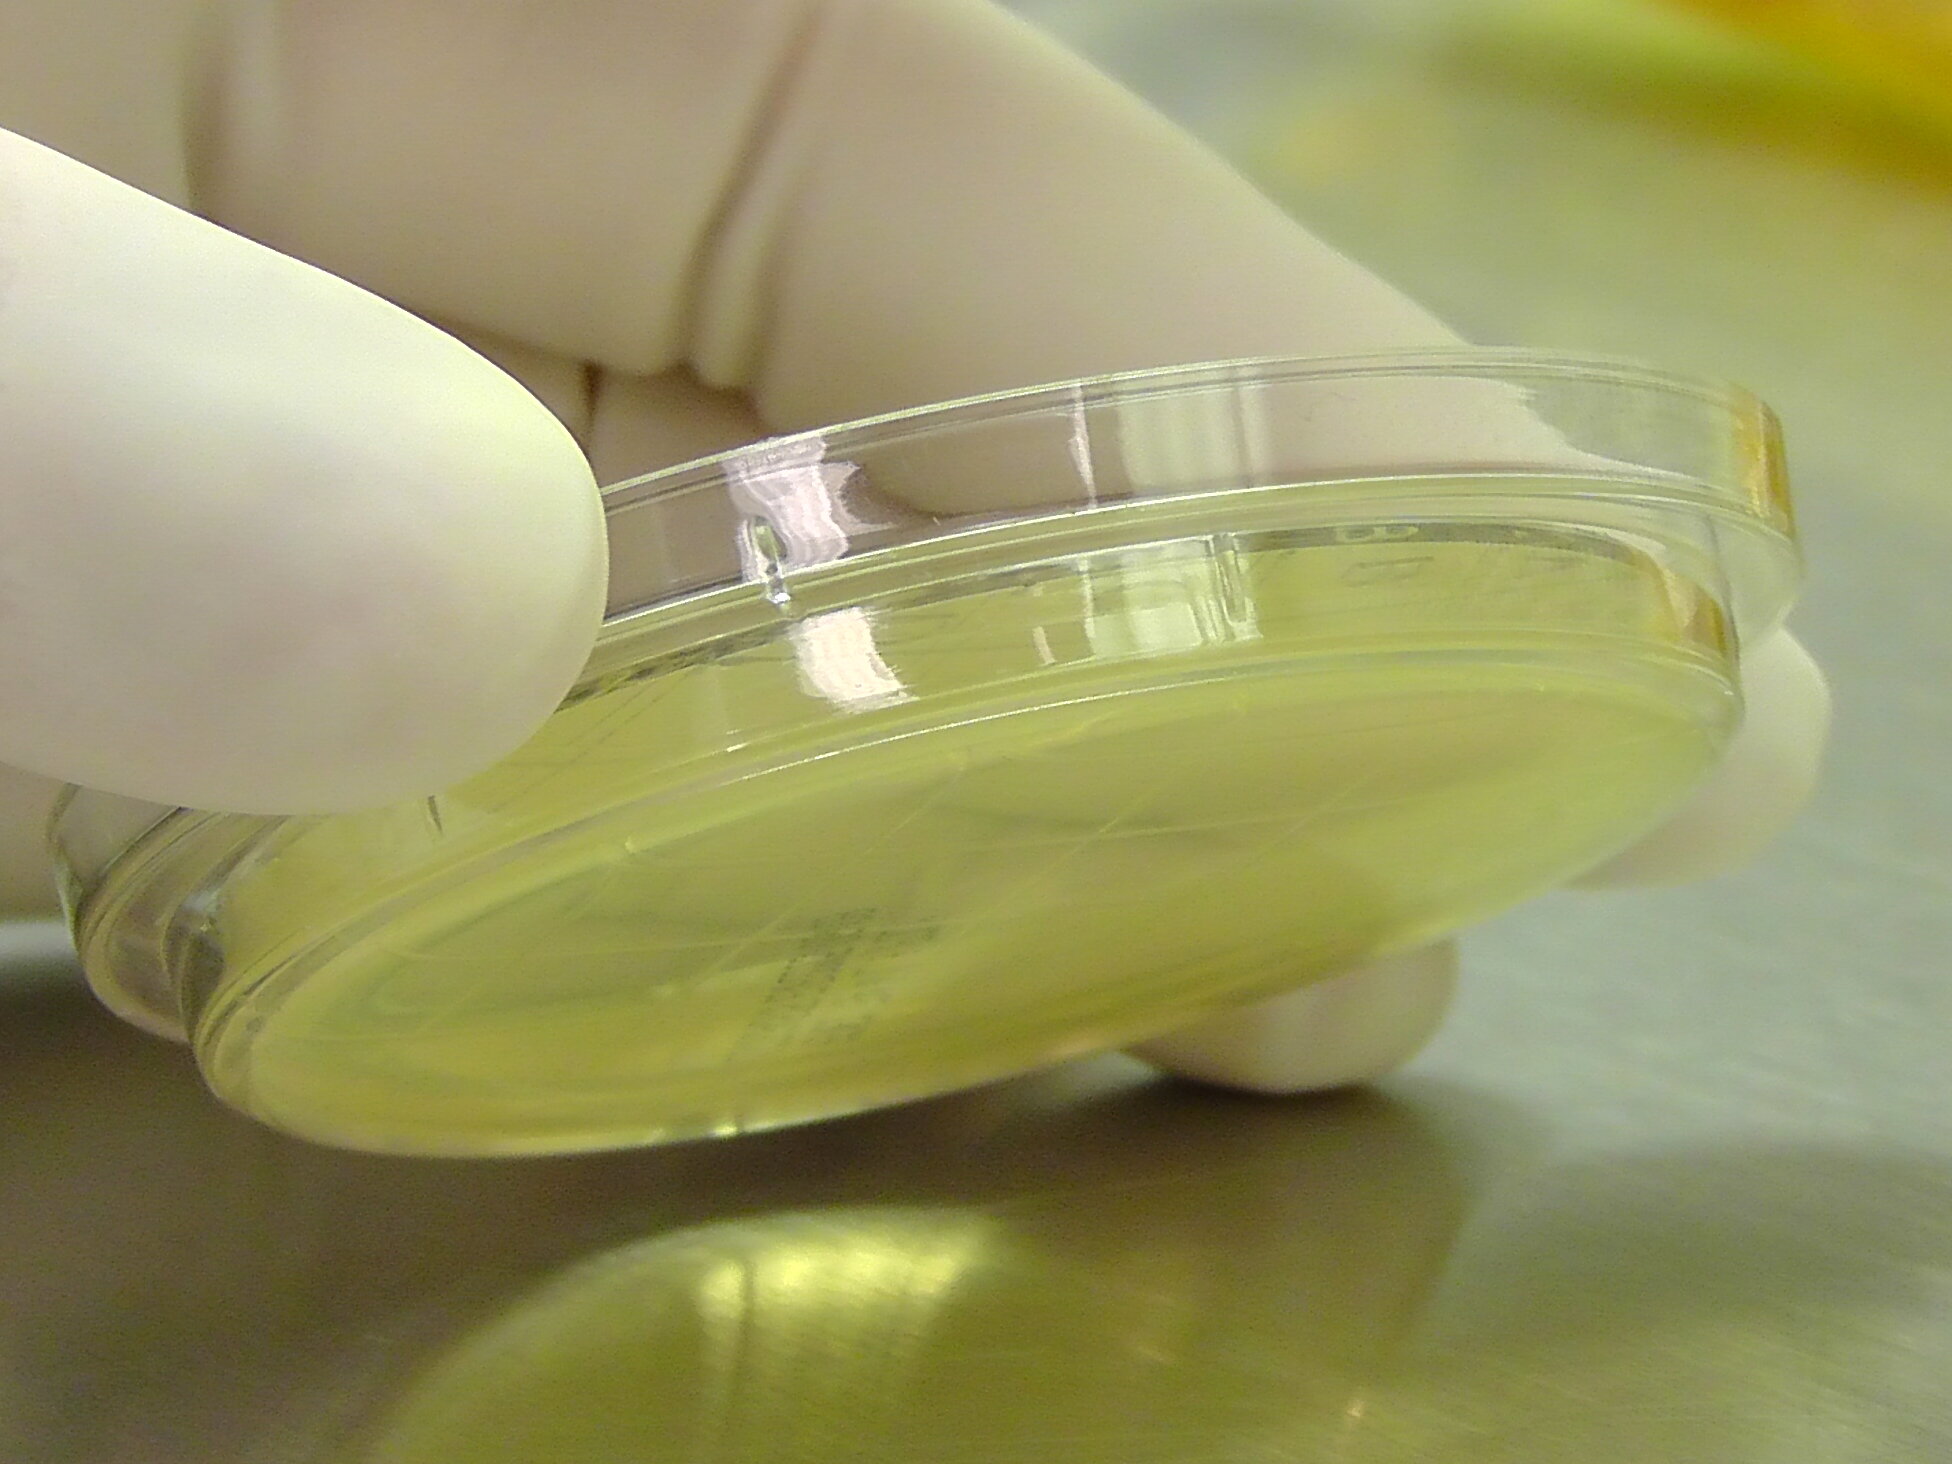
ATC sampling

Cleanroom Testing & Certification
Precision Testing and Custom Solutions for Your Unique Cleanroom Needs...
How does it work?
Cleanroom Certification Testing
Cleanroom certification involves a series of tests to ensure that the environment meets specific standards for cleanliness and controlled conditions.
The key tests required for cleanroom certification.
Particle Count
Measures the number of airborne particles to verify that the cleanroom meets the required cleanliness class as per ISO 14644-1 or other relevant standards.
Airflow Velocity and Uniformity
Assesses the speed and uniformity of the airflow within the cleanroom to ensure it is within specified limits.
HEPA/ULPA Filter Leak
Detects leaks in High Efficiency Particulate Air (HEPA) or Ultra Low Penetration Air (ULPA) filters to ensure their integrity and efficiency in trapping particles.
Air Pressure Differential
Measures the pressure difference between the cleanroom and adjacent areas to ensure that the cleanroom maintains the correct positive or negative pressure.
Temperature and Humidity
Verifies that temperature and humidity levels are within the specified range for the cleanroom's intended use.
Smoke Test
Uses smoke tests to visualize airflow patterns, ensuring that there are no dead spots or areas of turbulence that could affect cleanliness.
Microbial Sampling
- Methods include active air sampling (using devices like air samplers that draw in a known volume of air and impact it onto a growth medium) and passive air sampling (such as settle plates, where plates containing growth medium are exposed to air for a set period).
- Testing surfaces within the cleanroom for microbial contamination.
- Results are compared against cleanroom classification standards (like ISO 14644-1) and industry-specific guidelines to determine if the cleanroom meets the required microbial cleanliness levels..
Full Transparency

"We believe in keeping our clients fully informed at every step, ensuring clarity, trust, and confidence in all our interactions and services."
Our commitment to transparency and professionalism is reflected in every report we produce. Each document meticulously details the results of our testing for each cleanroom or clean zone, strictly adhering to ISO 14644-1 guidelines.
Our reports go beyond basic results, offering an in-depth look at our testing procedures. They provide a thorough overview of the methods used, the instruments employed, and their current calibration status, ensuring unparalleled precision and accuracy. Additionally, these reports offer detailed particle concentration data for each sampling location, giving you a complete picture of your clean area’s status. Armed with this extensive information, you can make well-informed decisions to maintain the highest standards of cleanliness and efficiency in your controlled environments.
